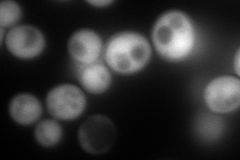
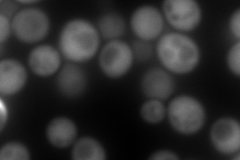

View description
ADP-ribosylation factor, GTPase of the Ras superfamily involved in regulation of coated formation vesicles in intracellular trafficking within the Golgi; functionally interchangeable with Arf1p
Localization:
Intensity:
Fold change:
Significance:
-
C’ GFP library in SD

below threshold15.33 -
N' NOP1pr-GFP in SD
cytosol316.655 -
N' TEF2pr-mCherry in SD
cytosol509.258 -
N' NATIVEpr-GFP in SD

cytosol145.178 -
N' TEF2pr-VC and Cyto-VN in SD

cytosol83.9447 -
C’ GFP library in SD+DTT

cytosol15.060.98No -
C’ GFP library in SD+H2O2

cytosol15.561.01No -
C’ GFP library in Starvation Media

cytosol17.051.11No -
C’ GFP library on the background of Pup2-DaMP

below threshold -
C’ GFP library on the background of CCT mutant

below threshold15.37291.00272No
